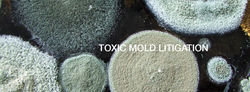
CC26.jpg

top of page
|
|---|
 |
 |
 |
 |
 |
 |
Honorable Burton S. Katz, Ret.
contact us
1 310 277 1077
Los Angeles Office
Burton Katz Mediation
2220 Avenue of the Stars
Los Angeles, CA 90067
CALL FOR A FREE CONSULTATION
CALL FOR
latest news
practice areas
WORD OF MOUTH
Described by his clients as “smart, focused, creative, engaging, nonthreatening, empathetic and firm when he needs to be.”
ARC Alternative Dispute Centers
bottom of page


